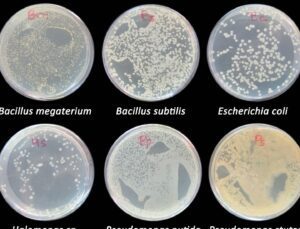
placas petri con colonias bacterianas a diferentes temperaturas

Contaminación secundaria: tipos y ejemplos para tomar en cuenta
La contaminación secundaria es un problema ambiental que afecta a todo el mundo. En este artículo, te explicamos qué es la contaminación secundaria, los diferentes tipos de contaminación secundaria y algunos ejemplos para que puedas tomar en cuenta su impacto en nuestra salud y en el medio ambiente. ¿Qué es la contaminación secundaria? La contaminación […]
Contaminación secundaria: tipos y ejemplos para tomar en cuenta Read More »